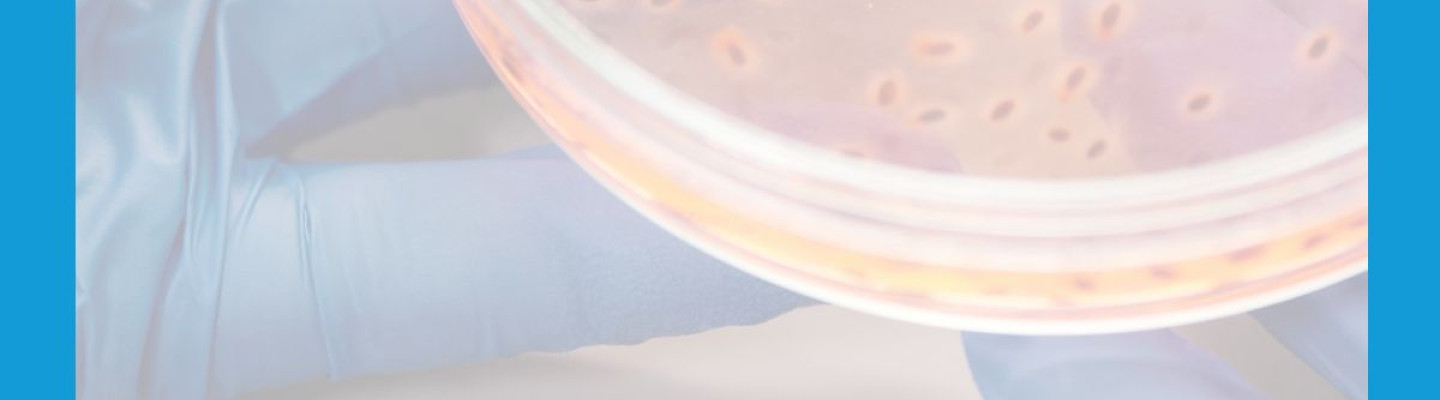
Innowacyjny producent podÅoÅ¼y mikrobiologicznych w ofercie Bionesis

Podłoża mikrobiologiczne odgrywają kluczową rolę w nowoczesnej diagnostyce mikrobiologicznej, umożliwiając szybką i precyzyjną identyfikację patogenów w próbkach klinicznych, przemysłowych i środowiskowych. W ofercie firmy Bionesis znajdują się wysokiej jakości produkty czeskiego producenta Viamar International s.r.o., który od ponad dwóch dekad dostarcza rozwiązania dla laboratoriów mikrobiologicznych w całej Europie. Wpisując się w strategię oferowania klientom wyłącznie sprawdzonych, certyfikowanych rozwiązań, Bionesis udostępnia szeroką gamę chromogennych podłoży diagnostycznych marki PureChrom – zarówno do izolacji bakterii Gram-ujemnych, jak i Gram-dodatnich, w tym szczepów wieloopornych.
Viamar – doświadczenie i jakość
Viamar International, założona w 1996 roku, początkowo specjalizowała się w doradztwie w sektorze ochrony zdrowia, farmacji i restrukturyzacji spółek prywatnych. Od 2000 roku firma skoncentrowała się na produkcji i sprzedaży podłoży mikrobiologicznych, a w 2009 roku otworzyła nowoczesne laboratorium produkcyjne we współpracy z Bio-Rad. Aktualnie współpracuje również z firmą BioVendor, co świadczy o uznaniu jej standardów jakości przez renomowane europejskie marki.
Do produkcji wykorzystywane są surowce od światowych liderów – Bio-Rad, Oxoid, Becton Dickinson, Laboratorios Conda – a cały proces odbywa się w warunkach ścisłej kontroli jakości, w pomieszczeniach wyposażonych w systemy HEPA, lampy UV oraz ściany pokryte powłoką bakteriobójczą. Każda partia produktu podlega testom przez certyfikowane laboratoria zewnętrzne, a chłodniczy transport zapewnia ciągłość łańcucha chłodniczego w temperaturze 2–8°C.
Podłoża PureChrom – charakterystyka i zastosowanie
W ofercie Bionesis dostępne są najczęściej wykorzystywane w praktyce klinicznej podłoża chromogenne Viamar pod marką PureChrom, które łączą wysoką czułość diagnostyczną, łatwość interpretacji wyników oraz zoptymalizowane warunki wzrostu mikroorganizmów.
PureChrom UTI
Chromogenne podłoże diagnostyczne do identyfikacji bakterii układu moczowego. Pozwala na różnicowanie kolonii dzięki obecności substratów rozkładanych przez enzymy specyficzne dla Escherichia coli, Enterococcus spp., Proteus spp. i innych. Kolor kolonii (np. fioletowy, zielony, brązowy) ułatwia rozróżnienie patogenów. Idealne do szybkiej diagnostyki ZUM.
PureChrom VRE
Selektywne podłoże do wykrywania enterokoków opornych na wankomycynę (VRE). Dzięki dodatkom selektywnym i barwnikom chromogennym, możliwa jest izolacja kolonii VRE już po 24 h inkubacji. Podłoże stosowane jest w kontroli zakażeń szpitalnych oraz badaniach przesiewowych.
PureChrom Candida
Podłoże dedykowane do identyfikacji drożdżaków z rodzaju Candida, zarówno w rutynowej diagnostyce, jak i w badaniach przesiewowych. Umożliwia różnicowanie gatunków dzięki wyraźnemu zabarwieniu kolonii. Szczególnie przydatne w diagnozowaniu zakażeń grzybiczych u pacjentów z obniżoną odpornością.
PureChrom ESBL
Podłoże umożliwiające izolację szczepów produkujących β-laktamazy o rozszerzonym spektrum (ESBL). Stanowi nieodzowny element diagnostyki zakażeń wywołanych przez wielooporne szczepy Enterobacteriaceae. Pomaga w identyfikacji szczepów ESBL w krótkim czasie i wspiera decyzje terapeutyczne.
PureChrom StrepB
Selektywne podłoże do izolacji paciorkowców grupy B (Streptococcus agalactiae), szczególnie przydatne w badaniach przesiewowych kobiet ciężarnych. Skuteczna identyfikacja Streptococcus agalactiae pozwala na ograniczenie ryzyka infekcji noworodka.
Dlaczego warto wybrać produkty Viamar od Bionesis?
Wybierając produkty Viamar International z oferty Bionesis, otrzymujesz:
-
Gotowe do użycia podłoża mikrobiologiczne o wysokiej czystości
-
Produkty spełniające normy ISO i GMP
-
Gwarancję ciągłości łańcucha chłodniczego
-
Elastyczność – możliwość produkcji na indywidualne zamówienie
-
Wsparcie merytoryczne i techniczne od zespołu specjalistów Bionesis